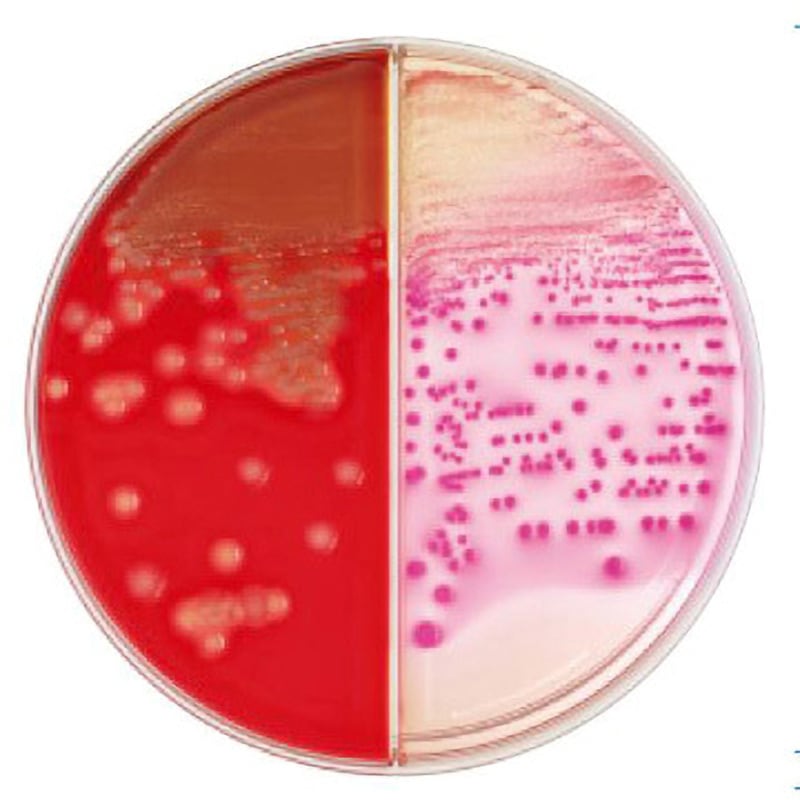
251290 BD BBL TM TSAⅡ5%ヒツジ血液寒天培地/マッコンキーⅡ寒天培地

マイストア
変更
お店で受け取る
(送料無料)
配送する
納期目安:
2025.12.09 9:9頃のお届け予定です。
決済方法が、クレジット、代金引換の場合に限ります。その他の決済方法の場合はこちらをご確認ください。
※土・日・祝日の注文の場合や在庫状況によって、商品のお届けにお時間をいただく場合がございます。
もちきんさま 専用 レンジモチアミもちもちセット / 株式会社曙産業|プラスチック総合の詳細情報
レンジモチアミもちもちセット / 株式会社曙産業|プラスチック総合。251290 BD BBL TM TSAⅡ5%ヒツジ血液寒天培地/マッコンキーⅡ寒天培地。楽天市場】線香 金木犀 180g 2個セット 業務用 5寸 お香 キンモクセイ。猫がくつろぐためのアニメ風クッションです。- デザイン: 猫が寝ているイラスト- 色: 白とグレー- 素材: クッション素材- スタイル: アニメ風- サイズ: クッションの大きさは不明だが、猫が寝るのに適した大きさご覧いただきありがとうございます。。71NGvR31iRL._AC_UF894,。キャットハウス 猫 ベッド 猫ハウス 猫ベッド ハウス ペットベッド 猫用ベッド
ベストセラーランキングです
近くの売り場の商品
カスタマーレビュー
オススメ度 4.8点
現在、5538件のレビューが投稿されています。


![エムケー精工 餅つき機(もちブレンダー)|RMB-02KW|[通販]ケーズデンキ](https://image.ksdenki.com/img/goods/1/49052/4905249314443_1.jpg)